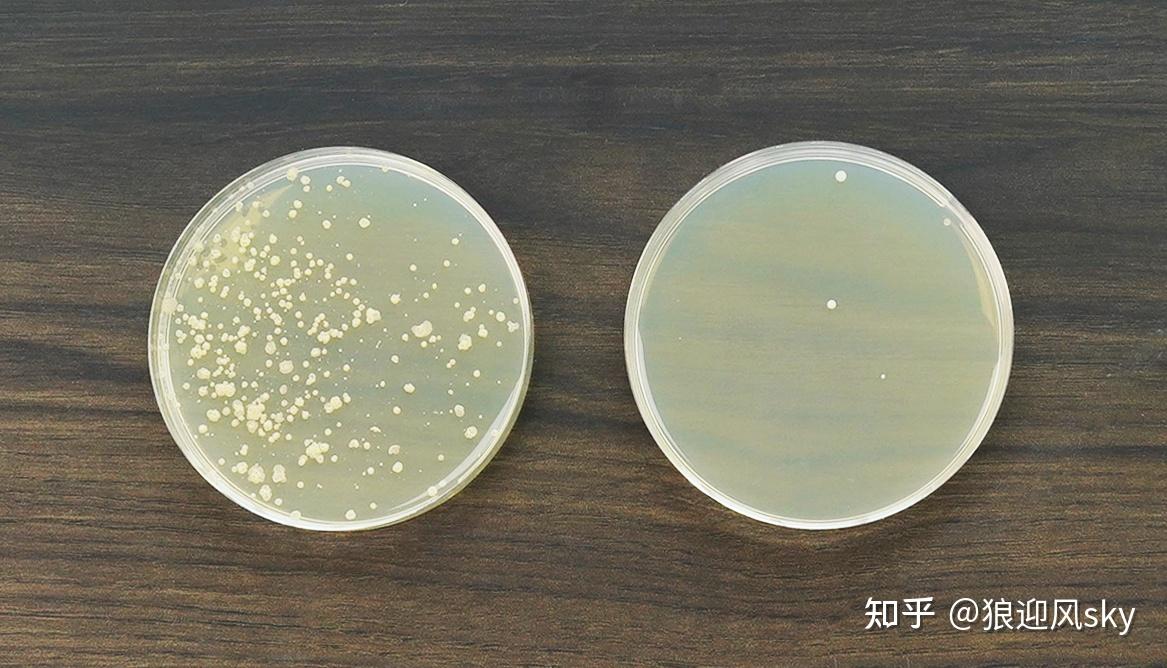
5款国内外大牌空气净化器深度数据测评,怎么选最适合你家?-各大空气净化器评测视频

我们都知道空气净化器可以去除甲醛和PM2.5等污染物,但是除了选择甲醛净化数值与净化功能之外,还有哪些要点是一般大众容易忽略的?哪些功能是厂家隐而不宣的秘密劣势?这篇文章带你看仔细了!
前言摘要
5个品牌、3位专家、耗时60天以上
本期空气净化器测评,感谢京东环境电器提供数据支持;感谢中国室内空气协会张主任和李科员提供技术指导、检测设备校准以及对测评结果的监督核实。
原计划耗时1周的空气净化器测评,为还原真实的测试环境,并确保严谨的测试结果,足足多花了2个月才得以完成。

符合居家应用需求的4大维度评分:
甲醛净化能力PM 2.5识别灵敏度除菌消毒效果后期滤芯使用成本解答93%的消费者购买空气净化器重点疑问:
空气净化器真的能除甲醛吗?如何判断空气净化器是否有效果?商家给出的净化数值越高,是好还是坑?随着测评的不断细化和两位专家指导下,亦意外发现了一些行业内幕。
测评品牌:飞利浦、霍尼韦尔、GA、舒乐氏、352
结合京东平台上的知名度、用户口碑和综合销量前20的净化器品牌,最终挑选了5款国内外品牌的空气净化器进行测评对比,具体如下:

▲ 参与测评的5款净化器
测试1:甲醛净化能力
家用机除甲醛,到底够不够力?
净化力效果作为空气净化器最重要的作用,而消费者关心的,还是空气净化器是否能持续地给予家中优良的空气环境。
【测试目标与评测标准】
因此我们测试两大能力:风量覆盖能力和甲醛净化能力,并且比照家用环境的需求,以净化的稳定性和持续效率作为评分标准。
5款净化器参数均符合国家标准,详细如下:

*理论上在同等空间环境下,CADR数值越大说明净化效率越高,CCM数据P4和F4属于国家标准最高等级,CCM数据越高说明滤网寿命越长。
风量覆盖能力:我家的空气循环力度好吗?
风量的大小,直接关系到室内空气的循环效果,也关联到净化器的净化速度和覆盖范围,所以首先从风量进行观测,可以较为直观的看到5款空气净化器的净化能力差别。
【风速测试】
5台空气净化器各有不同的出风档位,首先以最大档位进行测试。由风速仪显示的数字测试,最大档位出风的速度由高到低依序为:
飞利浦 > GA > 舒乐氏 > 霍尼韦尔 > 352
而在最小档位时,出风量的前2名为GA与舒乐氏。

▲ 风速仪测量展示

▲ 利用气球作为直观的风力展示

▲ 不同档位风量数据
甲醛净化能力:模拟真实家居环境测试
大部分所谓的测评人员,测试甲醛净化时,一般只在无遮挡物空间进行测试,脱离了一般大众的真实应用环境。
这样真能测试出实际甲醛净化效率效果吗?
对此,我们参考了《2021年度中国家庭客厅平均活动面积报告》,选取一个差不多50cm²的空间,模拟日常家居布置。

1、设置4个取样点
2、分别放置福尔马林溶液200ML来模拟甲醛
3、使用国家认证甲醛检测仪,实时记录数据
4、1个小时后,由5台净化器依次进行净化测试

甲醛净化力测试结果如下:

结论1:5款空气净化器均能达标
净化一小时后,5款空气净化器都能达到国家甲醛浓度(国标0.08以下)的最低数值标准。而GA空气净化器和舒乐氏达标只用了12分钟。而且也正如CADR的数据原理一样,CADR数值越大净化效率越高。

结论2:存在净化死角
霍尼韦尔和飞利浦在1号和3号测试点的数值依然偏高,最高的数值还在0.13,说明这两款净化效果并不能均匀覆盖空间。
但这样的测试就足够了吗?
实际使用时,空气净化器会一直处在持续的工作状态,一台新机的净化数值,其实并不能说明完整周期的净化效果。为了搞清楚空气净化器功能衰减的情况,我们让5款空气净化器持续工作了60天后,再重新进行了完整的测试。
60天后净化效率对比,结果出人意料
只有352和GA空气净化器效果让人满意霍尼韦尔和舒乐氏出现不同程度下降飞利浦竟然下降了18.3%说明个别品牌标榜甲醛净化数值虽然很高,但衰减情况也非常明显,大部分人都因为不了解,所以容易被商家错误引导(很有可能为了应对实验标准拉高了数值,偷偷钻的空子)。
“空气净化器并不是数值高效果就绝对好,还需要看净化持久力”
60天后甲醛净化力测试结果如下:

测试2:空气识别灵敏度
别让PM 2.5留在房子里太久
在PM2.5净化灵敏度测试中,我们进行日常二手烟的环境模拟。看侦测到烟雾后多久,空气净化器会开始工作。
在透明密封箱体中摆放空气净化器和空气质量检测仪,然后灌入同等分量的烟体,记录空气净化器从识别PM2.5到开始自动工作的时间、净化完成中间所花费的时间。
以下表格可以看到各品牌的数据,烟雾识别启动最快的是舒乐氏与GA。

*对烟雾识别用时越小,代表空气净化器的灵敏度越好;净化完成用时越短,代表空气净化器对PM2.5的净化效果越好。

▲ GA净化最快,飞利浦净化最慢
测试3:除菌消毒效果
家有宝宝、老人、呼吸系统敏感怎么选
市面上有多种杀菌技术皆可运用在空气净化器中,以下是本次评测品牌5款空气净化器的杀菌技术对比:
我们可以看到,所有机种都使用主流HEPA过滤网,其中GA所使用的滤网标示出,是选用阻挡率> 99.95%的H12等级滤网。除此之外,各家空气净化器依功能不同,采取不同杀菌技术。

此环节我们采用2002 年版 《空气消毒技术规范》中规定进行,用营养琼脂平板,来采集空气中的细菌,并统计细菌总数。
▲ 细菌培养前后对比
【可视化草莓测试】
为了给大家直观看到日常细菌的实际影响,我们在测试环境中同步放入了草莓,保持相同的温度和湿度,观察草莓放置2天的状态变化。
*小科普:选择草莓进行对比,是因为草莓在贮藏中最易受空气中灰霉、根霉、皮腐病菌等细菌影响,产生腐烂。
还可食用:舒乐氏、GA
通过肉眼观察草莓2天前后的对比发现,舒乐氏和GA空气净化器这两组的草莓依旧保持新鲜,还在可食用的状态。
出现霉变:飞利浦、霍尼韦尔、352
而飞利浦、霍尼韦尔、352这3组,已经分别出现了不同程度的发霉长白毛、萎缩和腐烂的情况,其中飞利浦的草莓最早出现霉变。
测试前的草莓状态:

2天后的草莓状态:

“大部分空气净化器都宣传除菌杀毒,然而只有小部分能做到”
【细菌总量】
回到实际菌数评测,空气中细菌总数最小排列为: GA > 舒乐氏 > 352 > 霍尼韦尔 > 飞利浦

测试4:使用成本
使用空气净化器,哪家滤网更划算
滤网是空气净化器的常用耗材,后续的使用成本,也是消费者重点关注的部分。根据京东旗舰店和客服提供的数据,我们对比5款空气净化器的滤网价格和寿命,结果如下:
将使用时长除以滤网价格,GA每天成本最划算,在1元左右。而最贵的是舒乐氏,每天耗材成本就需要接近2元了。

最终汇总:5大品牌测评得分

彩蛋
最后带来小彩蛋结束本次历时2个月的空气净化器测评,希望大家可以一如既往的支持我们。

▲ 3号GA和4号舒乐氏草莓试吃
除菌环节结束后,我们在5位小伙伴不知情的情况下,把剩下的舒乐氏和GA空气净化器这两组草莓分别进行了试吃投票环节(看着这么好的草莓也不好浪费啊),最后3号GA空气净化器这组的草莓有4个人认为整体口感较好。
问题解答环节
空气净化器真的可以去除甲醛吗?
张主任:是的,区别于传统被动型除醛的喷剂喷雾和固体活性炭,空气净化器属于主动净化型,通过带动室内空气的循环流动,加上针对甲醛吸附分解的滤网,是可以有效除醛。有条件可以开窗通风同时结合空气净化器来去除甲醛。怎么判断是否需要买空气净化器?
李科员:有以下几种情况有必要使用空气净化器:
1、新装修新家居
2、容易受空气漂浮物引起过敏症状
3、家中有吸烟者
4、室外有雾霾天气/灰尘大
5、家中有养宠物是不是CADR净化数值买越高的越好?
张主任:CADR净化数值越高说明净化效率也越高,但同时持久的净化能力同样重要,因为我们也发现有个别品牌会利用实验室环境标高CADR数值。选购空气净化器时应从实际需要出发,如非在高浓度污染的环境内使用,可以选择能将污染物下降到限值以下的产品即可,而无需一味追求高去除率并且价格昂贵的产品。
参考资料来源:
[1] 中华人民共和国国家质量监督检验检疫总局. GB /T 18801—2008 空气净化器[S]
[2] 李辉,孔庆媛,万毅,等.室内空气净化技术的研究与探讨[J]
[3] 潘碧云,李彦旭,王军. 活性炭吸附挥发性有机气体的影响因素[J]
[4] 张文彩 张波; 新型空气净化器的研制与应用[A]
[5]《光催化空气净化器效果实验报告》唐琳 柳振安
[6]《空气净化器对室内甲醛净化效果的实验研究》 田世爱,于自强
–
本次测评数据总表查阅:

– End-
免责声明:文章内容来自互联网,本站仅提供信息存储空间服务,真实性请自行鉴别,本站不承担任何责任,如有侵权等情况,请与本站联系删除。